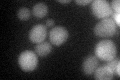
YNL090W
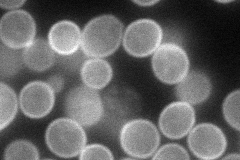
YNL090W
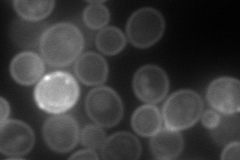
YNL090W
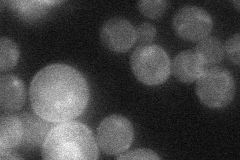
YNL090W
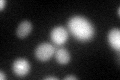
YNL090W
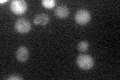
YNL090W

View description
Non-essential small GTPase of the Rho/Rac subfamily of Ras-like proteins, involved in the establishment of cell polarity and in microtubule assembly
Localization:
Intensity:
Fold change:
Significance:
-
C’ GFP library in SD
cytosol31.89 -
N' NOP1pr-GFP in SD
cell periphery80.8876 -
N' TEF2pr-mCherry in SD
cell periphery,vacuole132.472 -
N' NATIVEpr-GFP in SD
cell periphery25.6741 -
N' TEF2pr-VC and Cyto-VN in SD

#N/A0 -
C’ GFP library in SD+DTT
cytosol34.071.06No -
C’ GFP library in SD+H2O2

cytosol32.971.03No -
C’ GFP library in Starvation Media
cytosol29.670.93No -
C’ GFP library on the background of Pup2-DaMP

cytosol -
C’ GFP library on the background of CCT mutant

cytosol25.27550.792438No
